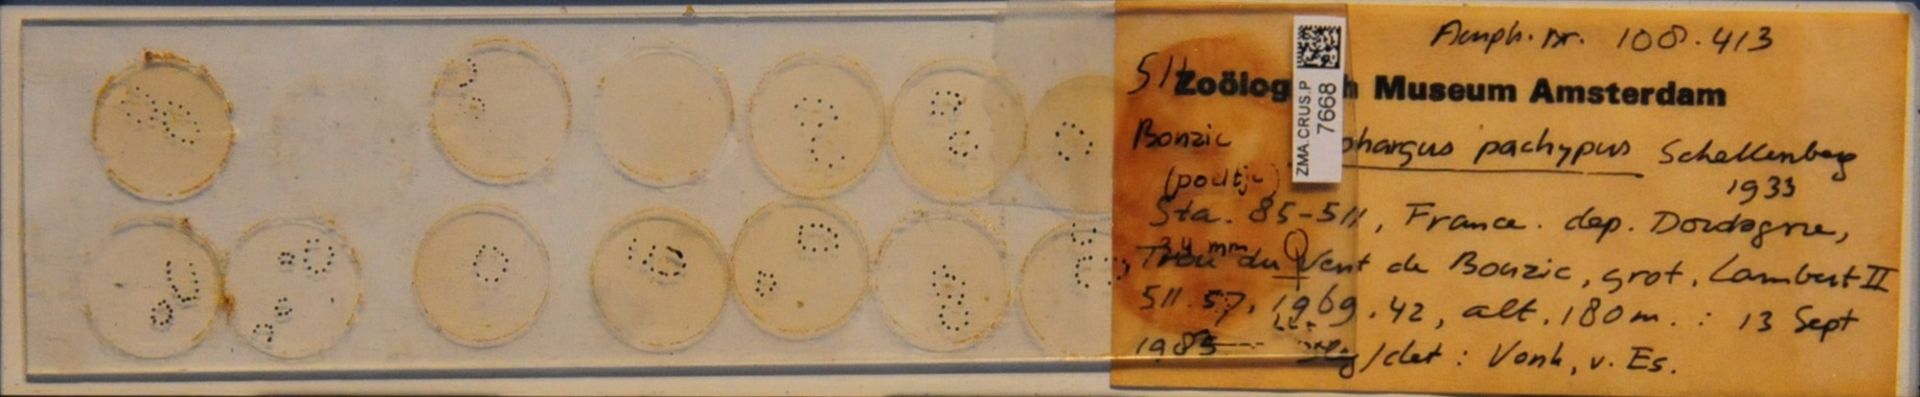

Espèces 17 à 32 sur 217
Gammarus roeselii
Gervais, 1835
235 occurrences
235 medias

Pectenogammarus simoni
Chevreux, 1894
2 occurrences
2 medias

Pectenogammarus spinulicornis
Pinkster & Stock, 1971
1 occurrences
1 medias

Pectenogammarus stammeri
S. Karaman, 1931
4 occurrences
4 medias

Niphargus aquilex
Schiødte, 1855
24 occurrences
24 medias

Niphargus caspary
Pratz, 1866
1 occurrences
1 medias

Niphargus corsicanus
Schellenberg, 1950
4 occurrences
4 medias

Niphargus dimorphopus
Stock & Gledhill, 1977
13 occurrences
13 medias

Niphargus fontanus
Bate, 1859
8 occurrences
8 medias

Niphargus kochianus
Bate, 1859
15 occurrences
15 medias

Niphargus ladmiraulti
Chevreux, 1901
1 occurrences
1 medias

Niphargus pachypus
Schellenberg, 1933
24 occurrences
24 medias
Niphargus plateaui
Chevreux, 1901
3 occurrences
3 medias

Niphargus rhenorhodanensis
Schellenberg, 1937
1 occurrences
1 medias

Niphargus schellenbergi
S. Karaman, 1932
6 occurrences
6 medias

Niphargus vandeli
Barbe, 1961
1 occurrences
1 medias
